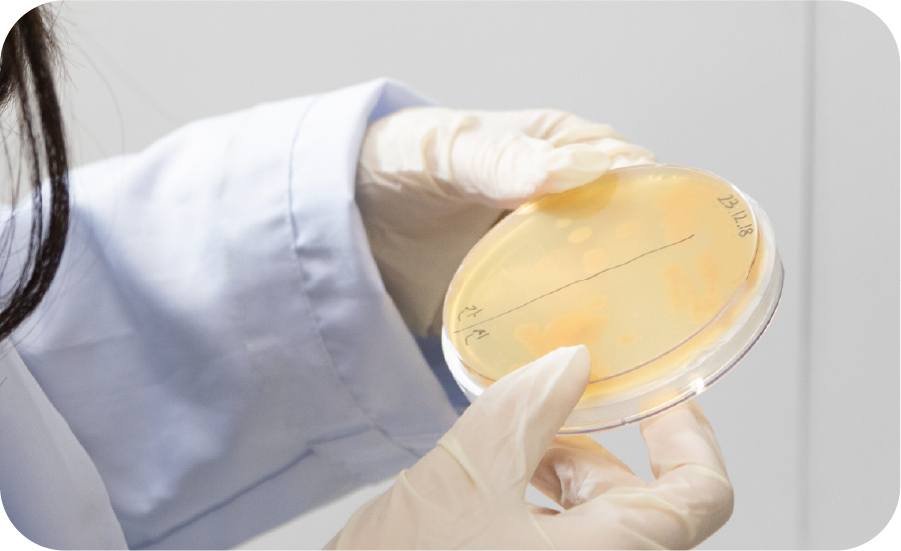

Abalone Porridge · Flounder Porridge
A porridge series made with 100%
Wando-sourced fresh abalone and
flounder
for wholesome, healthy flavor.



Fresh and Healthy
Convenience Food
Haesung International’s food brand Bokdream offers a variety of
well-balanced products
made with carefully selected ingredients
grown in Wando, Korea, renowned for its clean
and pristine seas.
HAESUNG INTERNATIONAL
Seafood Managed
by Aquatic Health
Experts

Through strict safety inspections and management, we provide seafood you can trust. All seafood handled by Haesung International is directly managed from stocking to harvest, ensuring freshness, health, and verified safety at every stage.
Safe Seafood
Haesung International uses only premium-quality ingredients sourced from the pristine waters of Wando,
Korea.
We provide fresh and safe seafood you can trust.